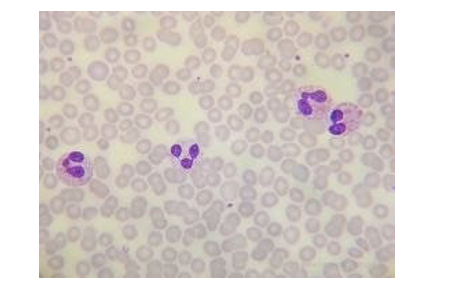

Afwijkende morfologie WBC
0.0(0)
Card Sorting
1/21
There's no tags or description
Looks like no tags are added yet.
Study Analytics
Name | Mastery | Learn | Test | Matching | Spaced |
|---|
No study sessions yet.
22 Terms
1
New cards

Vacuolisatie
2
New cards

Dohle bodies
3
New cards

Toxische korreling
4
New cards

degranulatie
5
New cards

hypersegmentatie
6
New cards
hyposegmentatie
7
New cards

Pelger huet
8
New cards

pseudonormoblast
9
New cards

virocyt
10
New cards

hairy cell
11
New cards

plasmacel
12
New cards

gumbrechtse schaduw
13
New cards

Auerstaaf
14
New cards

normale BP
15
New cards

Trombopenie/Trombocytose
16
New cards

Reuzentrombocyt
17
New cards

Aggregaten
18
New cards

satellitisme
19
New cards

AML
20
New cards

ALL
21
New cards

CML
22
New cards

CLL